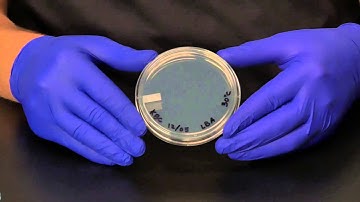
Instructional Video - Isolation Streak Plate
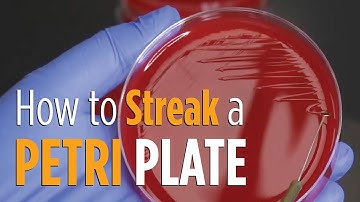
Four Quadrant Streak procedure - How to properly streak a Petri plate for isolated colonies

⬇ DOWNLOAD NOW
Kalau muncul iklan pop-up, tutup lalu klik tombol kembali
Download lagu Lab 2 Isolation streak plate technique secara gratis hanya untuk keperluan promosi. Dukung artis favorit kamu dengan membeli musik original di iTunes atau platform resmi lainnya.
 Streak Plate Technique for The Isolation of Pure Culture_A Complete Procedure (Microbiology)
Streak Plate Technique for The Isolation of Pure Culture_A Complete Procedure (Microbiology)
 GEN 131E Lab 2: Isolation Streak Plate Technique
GEN 131E Lab 2: Isolation Streak Plate Technique
 Lab technique microbiology: Streak plate method
Lab technique microbiology: Streak plate method
 LAPU Bio 225 week #2 isolation streak plate technique
LAPU Bio 225 week #2 isolation streak plate technique
 2 Streaking for Isolation--Subcultures--Staph Aureus
2 Streaking for Isolation--Subcultures--Staph Aureus
Instructional Video - Isolation Streak Plate
Instructional Video - Isolation Streak Plate
 Isolation Streak Plate
Isolation Streak Plate
Four Quadrant Streak procedure - How to properly streak a Petri plate for isolated colonies
Four Quadrant Streak procedure - How to properly streak a Petri plate for isolated colonies